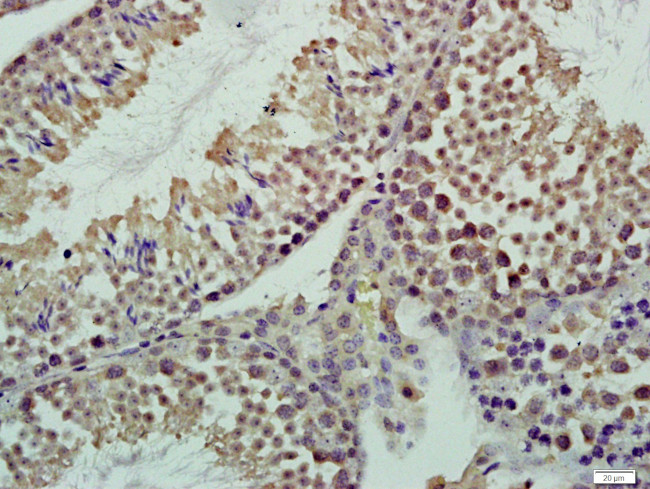
CASC5 Antibody in Immunohistochemistry (Paraffin) (IHC (P))

Search
Bioss
CASC5 Polyclonal Antibody
{{$productOrderCtrl.translations['antibody.pdp.commerceCard.promotion.promotions']}}
{{$productOrderCtrl.translations['antibody.pdp.commerceCard.promotion.viewpromo']}}
{{$productOrderCtrl.translations['antibody.pdp.commerceCard.promotion.promocode']}}: {{promo.promoCode}} {{promo.promoTitle}} {{promo.promoDescription}}. {{$productOrderCtrl.translations['antibody.pdp.commerceCard.promotion.learnmore']}}
图: 1 / 1
CASC5 Antibody (BS-5959R) in IHC (P)

产品信息
BS-5959R
种属反应
宿主/亚型
分类
类型
抗原
偶联物
形式
浓度
规格
纯化类型
保存液
内含物
保存条件
运输条件
靶标信息
Performs two crucial functions during mitosis: it is essential for spindle-assembly checkpoint signaling and for correct chromosome alignment. Required for attachment of the kinetochores to the spindle microtubules. Directly links BUB1 and BUB1B to kinetochores. Part of the MIS12 complex, which may be fundamental for kinetochore formation and proper chromosome segregation during mitosis. Acts in coordination with CENPK to recruit the NDC80 complex to the outer kinetochore.
仅用于科研。不用于诊断过程。未经明确授权不得转售。
篇参考文献 (0)
生物信息学
蛋白别名: AF15q14; ALL1-fused gene from chromosome 15q14 protein; Blinkin; blinkin, bub-linking kinetochore protein; Bub-linking kinetochore protein; cancer susceptibility candidate 5; Cancer susceptibility candidate gene 5 protein; Cancer susceptibility candidate gene 5 protein homolog; Cancer/testis antigen 29; CT29; D40; kinetochore null 1 homolog; Kinetochore scaffold 1; Kinetochore-null protein 1; microcephaly, primary autosomal recessive 4; Outer kinetochore KNL1 complex subunit KNL1; Protein CASC5; Protein D40/AF15q14; protein phosphatase 1, regulatory subunit 55; RAD51 homolog
基因别名: 2310043D08Rik; 5730505K17Rik; AF15Q14; CASC5; CT29; D40; hKNL-1; hSpc105; KIAA1570; KNL1; MCPH4; PPP1R55; Rad51; Spc7
UniProt ID: (Mouse) Q66JQ7, (Human) Q8NG31
Entrez Gene ID: (Mouse) 76464, (Rat) 311327, (Human) 57082